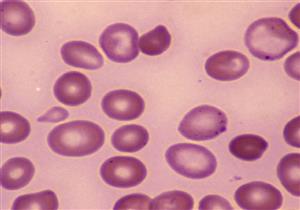
نقص فيتامين B12: 6 علامات لاحتمال تعرضك للإصابة بفقر الدم الخبيث

إعلان
-
11 مارس, 2021
إعلان
-

"أموال وأراضي ساحلية".. ما هي مكافآت لاعبي السنغال بعد التتويج بأمم أفريقيا؟
-

غياب صلاح.. التشكيل المثالي لكأس الأمم الأفريقية 2025
-

تعليق مفاجئ من عمرو زكي بخصوص محمد صلاح في كأس الأمم الأفريقية
-

"صفقة الأهلي المحتملة".. تعليق حزين من يوسف بلعمري بعد هزيمة المغرب في
-

ساديو ماني يكشف كواليس مكالمته مع رونالدو بعد التتويج بأمم أفريقيا
أخبار منتخبات كأس الأمم الأفريقية

إعلان